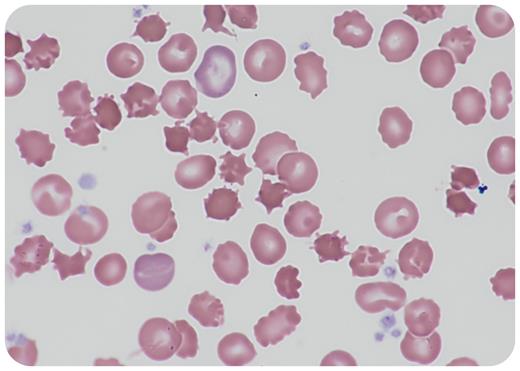
graphic

A hypotrophic full-term baby girl presented with feeding difficulty and severe failure to thrive at 8 days of age. Intensive diagnostic workup revealed low levels of vitamin K, despite regular supplementation. Automated blood counts were normal. However, microscopic evaluation of blood smear at 7 weeks of age revealed acanthocytosis (40× objective; total magnification ×400), which eventually led to suspicion of abetalipoproteinemia. Extremely low total cholesterol and triglyceride levels, absent of low-density lipoprotein cholesterol and apolipoprotein B in plasma, and reticulocytosis (107 000/μl) supported the diagnosis. A low-fat diet and supplementation of fat-soluble vitamins were initiated. Compound heterozygous mutations of the MTTP gene confirmed the diagnosis.
Abetalipoproteinemia is an extremely rare inherited disorder caused by a biallelic MTTP mutation and is characterized by the malabsorption of fat and fat-soluble vitamins and severe hypolipidemia. The MTTP gene encodes the large subunit of microsomal triglyceride transfer protein. Patients typically manifest with steatorrhea, vomiting, and failure to thrive in infancy, and they develop serious neurological and ophthalmological complications if left untreated. Hematological features are characterized by acanthocytosis, resulting from alterations in erythroid membrane lipids and proteins, and hemolytic anemia. Early diagnosis and intervention with high-dose vitamin supplementation are critically important to prevent severe complications and improve the prognosis. This case emphasizes the importance of microscopic evaluation of a blood smear for patients with an undiagnosed disease.
For additional images, visit the ASH Image Bank, a reference and teaching tool that is continually updated with new atlas and case study images. For more information, visit https://imagebank.hematology.org.